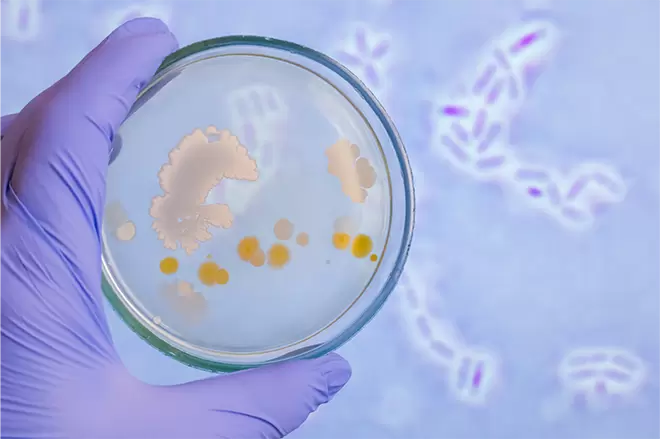

LRa05, originally isolated from healthy infants, supports digestion and immune health, and shows promising potential in women’s health—particularly in supporting metabolic wellness and promoting microbiota balance.
G-Serene— Gut, Glow, Grisso
Free shipping always.*
.png?w=902&h=400&q=80)


Adults. Take 1 Grisso® capsule daily, with or without food. Take at least 30 minutes after taking antibiotics.
Store in a cool, dry place. Avoid direct sunlight.
With daily use, noticeable benefits typically emerge within 4 weeks








Discover how we combine natural probiotics and botanical ingredients to gently care for overall feminine balance by maintaining healthy flora, pH, hormones, and urinary tract protection.









Probiotics Blends (270 mg, 100 Billion CFU)
Lacticaseibacillus rhamnosus LRa05 — 20 Billion CFU
Lactobacillus crispatus LCr86 — 5 Billion CFU
Lactobacillus gasseri LG08 — 10 Billion CFU
Bifidobacterium animalis subsp. lactis WKB99 — 20 Billion CFU
Lacticaseibacillus casei LC16 — 10 Billion CFU
Lactobacillus acidophilus LA18 — 5 Billion CFU
Bifidobacterium longum subsp. longum BL21 — 10 Billion CFU
Lactiplantibacillus plantarum Lp90 — 20 Billion CFU
Other Functional Ingredients (130 mg)
Microcrystalline Cellulose — 38 mg
Cranberry Powder — 40 mg
Inulin(from Chicory Root) — 50 mg
Magnesium Stearate — 2 mg

Your beneficial strains begin to establish themselves in the gut and vaginal microbiome, laying the foundation for long-term balance. Early support starts at the microbial level.
With consistent daily use, many women start to notice improvements. Vaginal flora may feel more balanced, with less odor or irritation, and urinary comfort can improve. Digestion may also feel smoother and more regular.
Continued use supports a more balanced vaginal, urinary, and gut microbiome. Women who experience recurring imbalances often notice fewer flare-ups and more consistent overall comfort.



Many users begin to notice changes in overall comfort and regularity within 1–3 weeks, though everyone’s experience is different. The benefits you feel early on—such as reduced bloating or more predictable digestion—are simply the most noticeable ones.
It’s also normal to experience mild digestive shifts within the first 48 hours as your body adjusts. Other areas of support—like gut–immune interaction—typically develop gradually and may not create a clear “felt” sensation. This is completely normal.
With consistent daily use, the beneficial microbes continue working in the background to help maintain a balanced and resilient internal environment.







